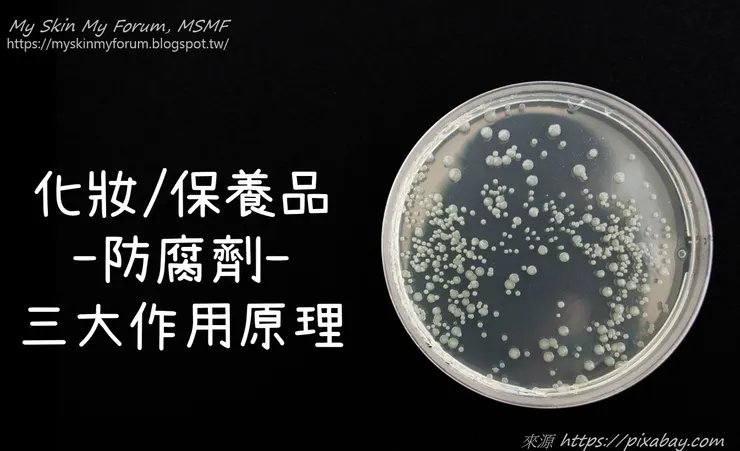
vocus｜新世代的創作平台

「防腐劑」是必要的──你不會希望,正在使用的保養品,變成〝微生物-養殖場〞,培養越來越多的細菌/黴菌,然後擦在自己臉上──所以,化妝品防腐劑,基本以「三大作用原理」來幫忙...
延續前面《保養品配方的五大結構組成 @MSMF 知識PART》介紹──「水&多元醇」
為什麼化妝保養品,一定要使用防腐劑?
從使用端來看
由於不可能〝強制〞消費者以「無菌操作」方式,使用化妝保養品──所以,每一次打開瓶蓋(內料直接暴露環境中)、或手指沾取保養品(內料),就等於提供外界微生物〝移民〞機會,持續性地污染保養品。然後這些小小的細菌(或黴菌/病毒等),就可以在這充滿〝生長養分〞的保養品中,快樂地生長繁衍──化妝保養品變成〝微生物的養殖場〞──於是隨著〝使用時間/次數〞增加,使用保養品的同時,也在臉上/皮膚上,擦上越來越多的〝微生物+微生物代謝廢物+微生物屍體碎片〞。
結果:不提產品「是否還保有原先的訴求功效?」──這些〝外來侵略者〞微生物「還可能引發嚴重的疾病感染風險。」例如:每隔一陣子,就會出現在新聞中,類似「化妝性眼病」的案例報導《化妝的美女們,你的睫毛膏開封多久了?茄病鐮刀菌,來了解一下!》──因為使用了〝被微生物污染〞的產品,美容保養不成,反遭受更嚴重的傷害(報導中睫毛膏,有致〝眼睛失明〞的危險)。
從製造端來看
雖然合格的化妝保養品廠,製造環境絕對符合GMP(Good Manufacturing Practice)要求──但從:原料儲存→調製/量產→充填/包裝→貨運/配送途中→倉儲/貨架上→消費者開封使用──這整個過程中,都可能因為各式各樣的意外因素,導致產品品質受損。
加上,外用的皮膚保養品,往往不可能與〝藥品規格〞相當──不管是廠房/產線配置、或使用一次性/拋棄式容器......等──所以,化妝保養品〝配方架構〞中,搭配適當的「防腐體系」(不見得完全依靠〝法定防腐劑〞成分),是非常有必要的。
唯有「防腐(劑)」合法使用下──才能合乎實際──滿足消費者〝美容保養需求〞,同時盡可能削弱〝對消費者的感染風險〞。
化妝保養品「防腐劑~三大作用原理」
1.破壞細胞膜──改變通透性,滲透壓無法維持;或養分攝取、代謝廢物排除,運作停止。包含:
- 有機酸類──如:己二烯酸和其鹽類(Sorbic Acid and Sorbates)、苯甲酸和其鹽類(Benzoic Acid and Benzoates)、去水醋酸鹽(Dehydroacetic Acid)、丙酸和丙酸鹽(Propionic Acid and Propionates)、水楊酸和其鹽類(Salicylic acid andSalicylates)、茴香酸(Anisic acid)......等。
- 芳香族化合物類──如:苯甲醇(Benzyl Alcohol)、苯氧乙醇(Phenoxyethanol)、對羥基苯酸酯類(Paraben)......等。
- 陽離子表面活性劑──如:聚氨丙基雙胍(Polyaminopropyl Biguanide)、苯扎氯銨(Benzalkonium chloride) 、季銨鹽-73(Quaternium-73,別名感光素 201)......等。
另外,非「法定」的化妝品防腐劑者,如:
- 多元醇──戊二醇(Pentylene glycol)、乙基己基甘油(Ethylhexylglycerin)、辛甘醇(Caprylyl Glycol).......等,以 C5~C8 者最具細胞膜干擾效果。
- 抗菌肽──常見如:乳酸鏈球菌素(Nisin)或表面素(surfactin)......等,能在微生物細胞膜上製造「孔洞(pore)」,破壞細胞內外滲透壓失衡,造成細胞死亡。
2.干擾微生物的酵素作用,抑制酵素活性,使其無法正常新陳代謝。例如:
- 乙二胺四乙酸(EDTA),能螯合金屬離子(如:Ca, Mg, Cu, Fe...等),影響酵素反應,干擾細胞代謝。
- 有機酸類防腐劑,使環境變酸,電解質失衡,造成蛋白質酵素變性,影響代謝;並迫使微生物浪費能量(ATP)去維持電解質平衡,缺乏能量正常生長。
3.使生物分子(如蛋白質、脂質與核酸等)變性,失去正常功能,細胞無法生長繁衍。包含:
- 甲醛緩釋類──如:DMDM 乙內醯脲(DMDM hydantoin)、雙烷基咪唑脲(Diazolidinyl urea)、咪唑烷基脲(Imidazolidinyl Urea)、烏洛托品(Methenamine)、季銨鹽-15(Quarternium-15)及羥甲基甘氨酸鈉(Sodium hydroxymethylglycinate)。
- 異噻唑啉酮類──如:甲基異噻唑啉酮(Methylisothiazolinon, MI)、甲基氯異噻唑啉酮(Methylchloroisothiazolinone, MCI)。
- 酚類(phenol)與含酚基化合物──如:苯氧乙醇(Phenoxyethanol)、對羥基苯酸酯類(Paraben)。
- 鹵素化合物──如:氯氟苯胺(Cloflucarban)、二氯苯氧氯酚(Triclosan,三氯沙)、碘丙炔醇丁基氨甲酸酯(Iodopropynyl butylcarbamate, IPBC)。
由於「微生物」與「人體細胞」的生化反應機轉,大同小異──所以在攻擊微生物的同時,也會誤傷皮膚,造成敏感刺激的副作用──從這個觀點來看:
防腐作用原理「安全性」比較:原理1、原理2 >原理3。
也因此,衛福部食藥署TFDA才會訂定《化粧品中防腐劑成分使用及限量規定基準表》,來確保化妝品使用者的健康安全。
只是隨著毒理學研究的累積與發展,化妝品的防腐劑規定,也會與時俱進──例如:TFDA民國 103 年版的《化粧品中防腐劑成分使用及限量規定基準表》僅表列 47 項,但到了新版(民國 107 年 4 月 1 日生效)已增為 69 項,同時更新了部分防腐劑的限量值、限用部位或警示內容等──然後,目前最新的草案版本(預計民國109年1月1日生效),則調整為57項。
所以,記得隨時更新相關訊息──以免錯用防腐劑(種類&%),發生潛在健康風險。
除了TFDA官網外,關於化妝品與原料相關安全性評估新資訊,可參考國際上較權威的兩個組織,其專家委員對化妝品原料的評估意見──這些意見,往往也會影響政府的法規變更。
總結:
保養品配方中之「防腐劑」是必要之惡──幫助維持「產品反覆使用期間」的品質;也是必要之善──有利「守護肌膚的健康」避免不必要的危險發生(微生物感染)。
*免費[試閱]索取→電子書《保養品DIY入門教戰手冊》
*My Skin My Forum, MSMF 【護膚保養品diy交流】 FB粉絲頁 &Youtube頻道
*成功配方=20%理論+80%實驗!





















